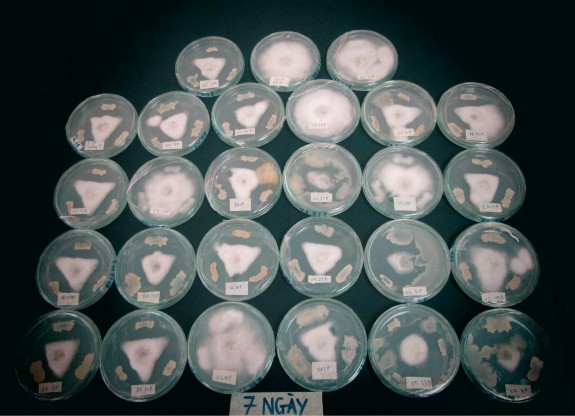
Hình 1 Hoạt tính kháng nấm Phyopthora của một số chủng vi khuẩn vùng rễ Hình 2
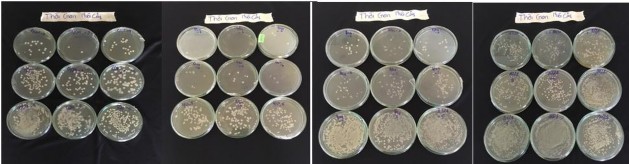
Hình 5 Ảnh hưởng của thời gian nhân giống và lên men đến mật độ chủng 8
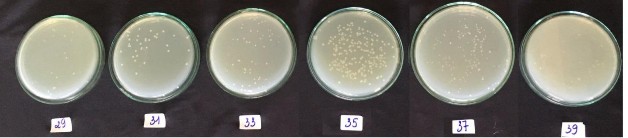
Hình 6 Ảnh hưởng của nhiệt độ đến mật độ chủng RB DS29 Hình 7 Ảnh 9
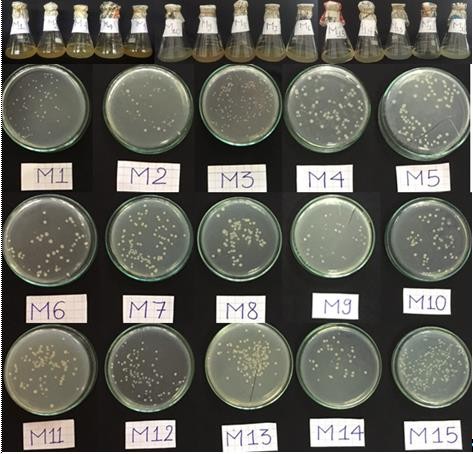
Hình 7 Ảnh hưởng của môi trường đến mật độ của chủng RB CJ41 Hình 8 10
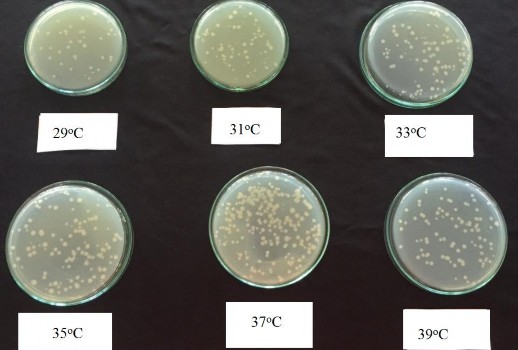
Hình 9 Ảnh hưởng của nhiệt độ đến mật độ của chủng RB CJ41 Hình 10 12
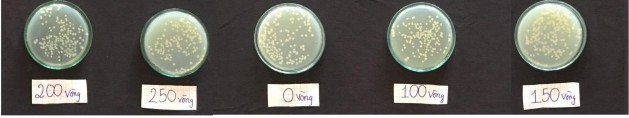
Hình 10 Ảnh hưởng của tốc độ lắc đến mật độ chủng RB CJ41 Hình 11 Ảnh 13
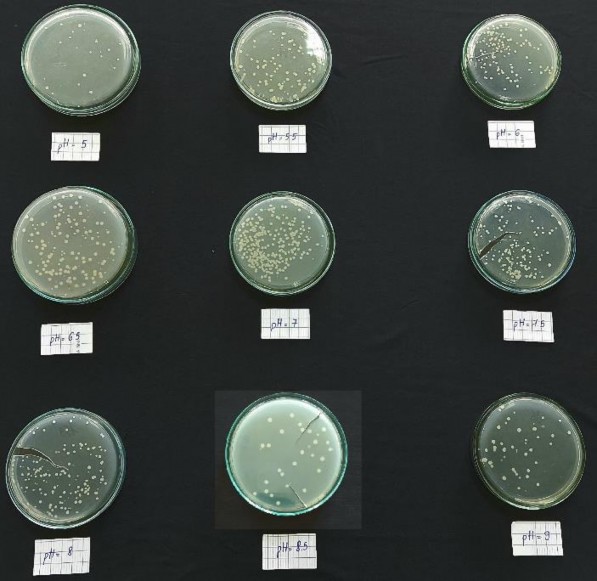
Hình 11 Ảnh hưởng của pH đến mật độ chủng RB EK7 12h 24h 36h Hình 12 Ảnh 14
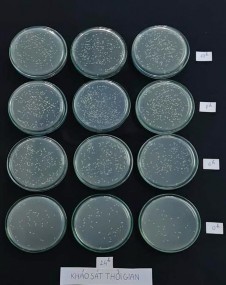
Hình 12 Ảnh hưởng của thời gian đến mật độ chủng RB EK7 Hình 13 Ảnh 18
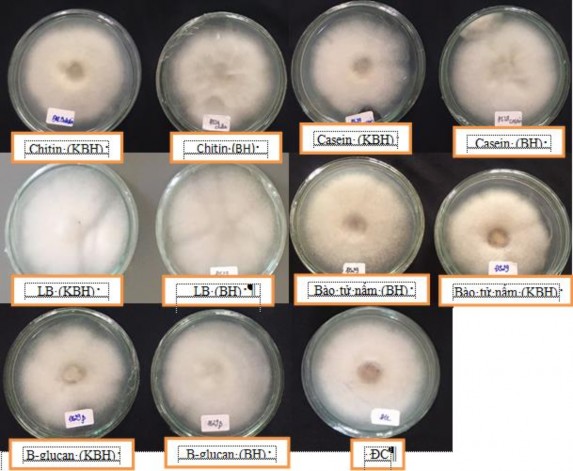
Hình 13 Ảnh hưởng của dịch nuôi cấy đến hoạt tính kháng Phytophthora Hình 14 19
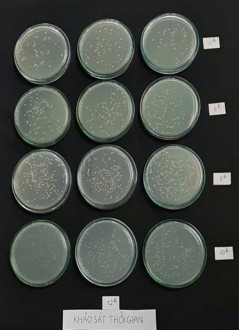
12h 24h 36h Hình 12 Ảnh hưởng của thời gian đến mật độ chủng RB EK7 Hình 13 15

PHỤ LỤC 5. HÌNH ẢNH
Hình 1. Hoạt tính kháng nấm Phyopthora của một số chủng vi khuẩn vùng rễ

Hình 2. Các nghiệm thức sau 90 lây nhiễm bệnh Phytophthora trong điều
kiện vườn ươm

Hình 3. Chiều cao cây và chiều dài rễ tiêu ở các nghiệm thức sau 90 ngày lây nhiễm Phytophthora trong điều kiện vườn ươm
A
B
Hình 4. A: Hình cây biểu hiện bệnh do Phytophthora B: Hình cây bị bệnh hoàn toàn
Bảng 1. Đặc điểm sinh hóa của chủng RB.DS29, RB.CJ41 và RB.EK7
P43

Hình 5. Ảnh hưởng của thời gian nhân giống và lên men đến mật độ chủng Bacillus velezensis RB.DS29
Hình 6. . Ảnh hưởng của nhiệt độ đến mật độ chủng RB.DS29
Hình 7. Ảnh hưởng của môi trường đến mật độ của chủng RB.CJ41

Hình 8. Ảnh hưởng của pH đến mật độ của chủng RB.CJ41
Hình 9. Ảnh hưởng của nhiệt độ đến mật độ của chủng RB.CJ41
Hình 10. Ảnh hưởng của tốc độ lắc đến mật độ chủng RB.CJ41
Hình 11. Ảnh hưởng của pH đến mật độ chủng RB.EK7
|
Có thể bạn quan tâm!
-
Két Quả Phân Tích Hợp Chất Kháng Phytophthora, Fusarium Và Tuyến Trùng Của Các Chủng Vi Khuẩn Tuyển Chọn Bằng Phương Pháp Gc – Ms Và Lc - Ms -
Xác Định Thành Phần Hóa Học Trong Dịch Nuôi Cấy Của Chủngvi Khuẩn Vùng Rễ Tuyển Chọn Có Khả Năng Kháng Nấm Fusarium Bằng Phân Tích Lc-Ms Và Gc-Ms -
Tuyển chọn, nghiên cứu đặc tính kháng tác nhân gây bệnh và tạo chế phẩm phòng trừ bệnh rễ của các chủng vi khuẩn vùng rễ cây hồ tiêu Piper nigrum L. tại Tây Nguyên - 26 -
Tuyển chọn, nghiên cứu đặc tính kháng tác nhân gây bệnh và tạo chế phẩm phòng trừ bệnh rễ của các chủng vi khuẩn vùng rễ cây hồ tiêu Piper nigrum L. tại Tây Nguyên - 28
Xem toàn bộ 224 trang tài liệu này.
36h |
Hình 12. Ảnh hưởng của thời gian đến mật độ chủng RB.EK7
Hình 13. Ảnh hưởng của dịch nuôi cấy đến hoạt tính kháng Phytophthora

Hình 14. Tác động của các hợp chất đã phân tách đến trứng và tuyến trùng